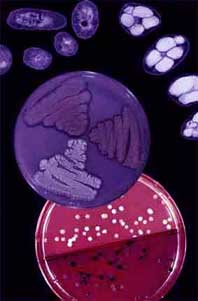

Grundlegendes zu den Zielen der Forschung im Arbeitskreis Steinbüchel
Die Forschungen des Arbeitskreises zielen darauf ab, physiologische, biochemische und molekular-genetische Grundlagen von Stoffwechselvorgängen und deren Regulation in Bakterien aufzuklären. Von besonderer Bedeutung sind hierbei Biosynthesen von chemischen Verbindungen, die für die Industrie relevant sind, sowie Abbau und Umwandlung nachwachsender Rohstoffe und preiswerter Verbindungen, die von der Landwirtschaft bereitgestellt werden oder als Abfall- sowie Reststoffe in der Wirtschaft anfallen. Im Idealfall kann beides miteinander verknüpft werden. Grundlagenforschung und angewandte Forschung sollen dabei eng verknüpft werden, um hierdurch zur Etablierung neuer und Verbesserung bereits existierender biotechnologischer Prozesse beizutragen bzw. um neue biotechnologische Produkte zu erzeugen und in ausreichenden Mengen für die Charakterisierung zur Verfügung zu stellen. Die Synthese von Biopolymeren (z. B. Polyester, Polyamide, schwefelhaltige Polymere), natürlichen Aromastoffen (z. B. Vanillin) und anderen Verbindungen (z. B. Lipide, Wachsester und 2-Methylcitrat) einerseits, sowie der biologische Abbau von Polymeren und deren Nutzung (z. B. Kautschuke, Polyethylenglycol, Polyamide und Braunkohle) und von niedermolekularen Verbindungen (z. B. Squalan, Iminodisuccinat, Acetoin) andererseits werden untersucht.
Aktuell: Arbeitskreis Steinbüchel bei 3Sat Nano (Oktober 2011).
Angewandte Methoden und Strategien:
-
Nutzung der Diversität von Mikroorganismen
-
Reinigung und Charakterisierung von Enzymen und anderen Proteinen
-
Klonierung und Charakterisierung von Genen
-
Modifizierung von Proteinen und Genen
-
Auswertung von Genomsequenzdaten
-
‚metabolic engineering'
-
In vitro Biosynthesen
-
Fermentationen in Bioreaktoren bis zum 500 L-Maßstab
-
Isolierung, Identifizierung und Charakterisierung von Stoffwechselprodukten
